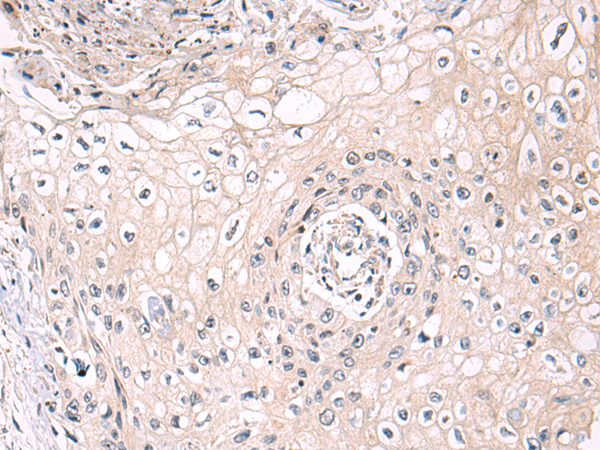
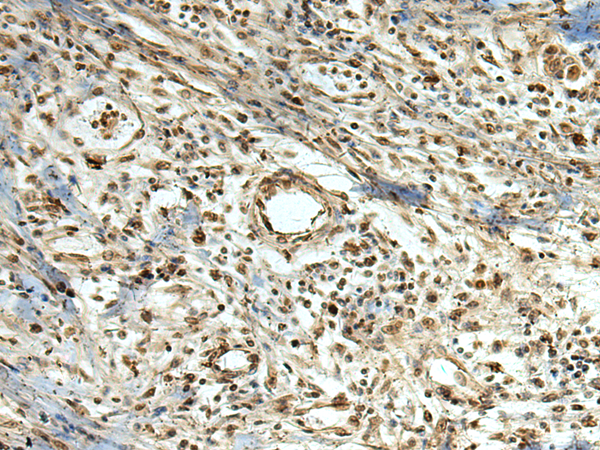

-
分类: 科研抗体货号: P03357别名: SAMP32应用: WB反应种属: Human
-
分类: 科研抗体货号: P03421别名: LPIPOX应用: WB,IHC反应种属: Human, Mouse
-
分类: 科研抗体货号: P03354别名: ICF45; IHG-1; hTHG1应用: IHC反应种属: Human, Mouse, Rat
-
分类: 科研抗体货号: P03416别名: ZAP75应用: IHC反应种属: Human
-
分类: 科研抗体货号: P03353别名:应用: IHC反应种属: Human, Mouse
-
分类: 科研抗体货号: P03400别名: SORD1; HEL-S-95n应用: IHC反应种属: Human, Mouse
-
分类: 科研抗体货号: P03349别名: C1orf71; PPP1R64应用: WB,IHC反应种属: Human, Mouse
-
分类: 科研抗体货号: P03397别名: FADS; CMS11; CMS4C; RAPSYN; RNF205应用: WB,IHC反应种属: Human, Mouse
-
分类: 科研抗体货号: P03348别名: CSS应用: WB,IHC反应种属: Human, Mouse, Rat
-
分类: 科研抗体货号: P03393别名: KMT1B应用: WB,IHC反应种属: Human, Mouse

鄂公网安备42018502007531号
鄂公网安备42018502007531号

